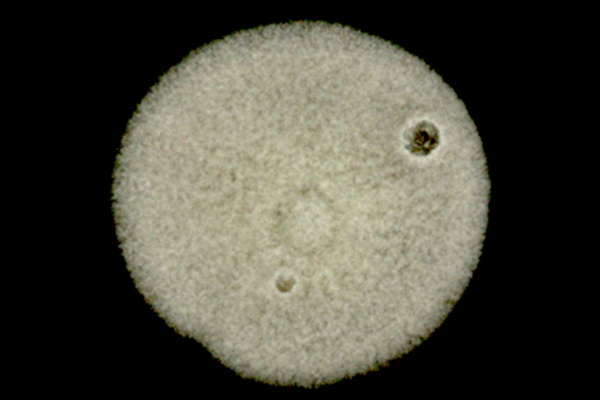
Foto eines Keims, mikroskopische Aufnahme

μQuant
Entwicklung eines KI-unterstützten und bildbasierten Systems zur quantitativen Analyse von Keimbelastungen
Projektlaufzeit: 01/2025 – 12/2026
Labortests für die Bestimmung von Bakterien-/Keimbelastungen zur Vorbeugung von Infektionskrankheiten sind in verschiedenen Bereichen verbreitet und häufig gesetzlich vorgeschrieben (z. B. Trinkwasseruntersuchung). Aus den Laborergebnissen müssen ggf. Maßnahmen abgeleitet werden, um Kontaminationen zu beseitigen oder Krankheiten zu therapieren. Dafür sind entsprechende Proben qualitativ (Keimartbestimmung) aber auch quantitativ (Anzahl Kolonie-bildender Einheiten (KbE)) innerhalb eines kurzen Analysezeitraums mit hoher Genauigkeit (Korrektklassifikationsrate) in großer Menge zu beurteilen, wobei keine kontaminierten Proben übersehen werden dürfen.
Eine wichtige Analysearte ist die makroskopische Untersuchung, wo die Proben nach ihrer Entnahme zunächst in Probenträger (z. B. Petrischalen) mit Nährmedien überführt und die enthaltenen Keime in einem Brutschrank (Inkubator) vermehrt und als KbE/Keimkolonien sichtbar werden. Für die makroskopische Bewertung werden die Anzahl der KbE, deren Größe, Farbe und Form sowie die Beschaffenheit der Oberfläche beurteilt. In den typischerweise kleinen bis mittelgroßen Laboren für Mikrobiologie erfolgt die Entnahme der Probenträger aus Probenstapeln, die Erfassung der Probenbeschriftung, die makroskopische Auswertung sowie das Zurücklegen in die Probenstapel meist manuell (ca. 2 min / Probe). Bei 300 bis 3000 Proben pro Tag ist dies zeit- und kostenintensiv und limitiert die untersuchbare Probenanzahl in Laboren. U.a. auch in Sachsen kann die Verfügbarkeit von qualifiziertem Personal aber derzeit oft nicht mit der hohen Auftragslage mithalten. Daher ist die Kapazitätserhöhung durch eine beschleunigte und automatisierte Probenanalyse ein zentrales Anliegen der Labore, was auch der Deutsche Verband Unabhängiger Prüflaboratorien e.V. (VUP) wiederholt hervorgehoben hat.
Das Gesamtziel ist die Erforschung und prototypische Entwicklung eines robotergestützten bildbasierten Analysesystems zur automatisierten Bewertung verschiedener mikrobieller Belastungen. Der kombinierte Ansatz besteht aus prototypischer Geräteentwicklung für die automatisierte makroskopische Bildgebung (Digitalisierung) von Proben, einer KI-basierten Bildanalyse und deren Integration in die Laborprüfprozesse. Das Analysesystem soll unabhängig vom konkreten Probenträgermodell und Probenbeschriftung (Barcode, Handschrift, etc.), flexibel hinsichtlich der Bildaufnahme (Auflicht/Durchlicht), sowie langfristig in unterschiedlichen Laboranwendungsdomänen (Humanlabore) einsetzbar sein und die Analysezeit signifikant reduzieren.
Förderung
EFRE

Kooperationspartner
- Kapelan Bio-Imaging GmbH (Koordinator)
- Institut für Angewandte Informatik e.V.
- Limbach Analytics GmbH
- Sondermaschinenbau Engelsdorf GmbH
Kontakt
Projektleitung
Prof. Dr.-Ing. Tilo Heimbold
Professur Prozessleittechnik und Prozessführung
Telefon: +49 (0)341 3076 1178
E-Mail: tilo.heimbold(at)htwk-leipzig.de
Team
M.Eng. Dipl.-Ing. Tobias Rudloff
Wissenschaftlicher Mitarbeiter
Telefon: +49 (0)341 3076 1277
E-Mail: tobias(dot)rudloff(at)htwk-leipzig.de
Team
M.Sc. Felix Tröger
Wissenschaftlicher Mitarbeiter
Telefon: +49 (0)341 3076 1022
E-Mail: felix(dot)troeger(at)htwk-leipzig.de